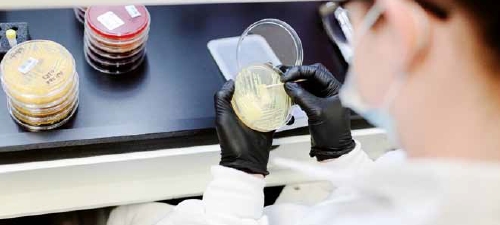

Para mantener una sala blanca eficaz y que cumpla con la normativa es esencial entender la Cualificación de la Monitorización Ambiental (EMPQ). Este artículo responde a las preguntas más habituales y aclara cómo las instalaciones de nueva construcción o significativamente renovadas pueden cumplir los rigurosos estándares microbianos y de partículas necesarios para productos seguros.
La Cualificación de una Monitorización Ambiental (EMPQ) sirve como paso previo a la validación del control ambiental, garantizando que las salas blancas y otros entornos controlados cumplen los estándares microbianos y de partículas necesarios para evitar la contaminación durante la producción. Este proceso mantiene la seguridad del producto y el cumplimiento de las normas reglamentarias.
¿Cuándo debe realizarse una EMPQ?
Una EMPQ se lleva a cabo en instalaciones de nueva sala, o en aquellas en las que se han realizados trabajos de renovación o cese de actividad de fabricación. Durante la EMPQ inicial se realizan muestreos ambientales para evaluar el microbiota presente antes de iniciar procesos de fabricación o desinfección.
Este proceso permite establecer una línea de base de nuestra flora, que puede variar en función de la geografía, los materiales utilizados para la construcción y (así como el modo de ejecutar dicha construcción. La variabilidad de la flora requiere un enfoque exhaustivo y adaptado al muestreo y al análisis. Los elevados costes asociados a los periodos de inactividad en la fabricación pueden aumentar la presión por parte de la dirección para poner en funcionamiento la sala. Este enfoque promueve la monitorización ambiental (EM) de forma rutinaria como parte de una estrategia eficaz de control de la contaminación (CCS) adaptada a las condiciones ambientales específicas de cada instalación.
¿Cómo una cualificación de la sala (EMPQ) facilita la identificación de la causa raíz de las posibles contaminaciones en zonas de fabricación de productos farmacéuticos?
Las EMPQ facilitan la identificación de las causas raíz de las posibles contaminaciones en zonas de fabricación mediante la aplicación de un programa de supervisión basado en los riesgos. Un programa de supervisión adecuado detecta las áreas potencialmente problemáticas. Realizar estudios adecuados de visualización del flujo de aire y comprender los flujos de personal, de materiales y de aire en el entorno de fabricación permite la identificación proactiva de las zonas de riesgo y facilita la localización y eliminación de cualquier posible fuente de contaminación.
¿Los requisitos de las salas blancas para la producción también son aplicables a las salas utilizadas en el control de calidad, como los ensayos de esterilidad?
Sí, los requisitos de las salas blancas para la producción también son aplicables a las salas utilizadas en el control de calidad, como las que se utilizan para los ensayos de esterilidad. Es importante mantener el mismo nivel de limpieza en todas las zonas de fabricación y seguir las normas, ya que los ensayos de esterilidad son tan críticos o más que los procesos de producción.
¿Qué factores conforman una estrategia válida de evaluación de riesgos?
Una estrategia válida de evaluación de riesgos se basa en varios factores. Primero, deben realizar actividades previas a la EMPQ, como el análisis de dinámica de fluidos computacional (CFD) y la visualización del flujo de aire, para identificar cualquier área de riesgo potencial. A continuación, es importante determinar si las actividades previas a la EMPQ se han realizado y ejecutado correctamente y si los riesgos potenciales se han identificado adecuadamente antes de desarrollar el protocolo completo. Comprender las zonas, los procesos, el personal y el flujo de materiales dentro de las áreas que se están evaluando también es esencial para una evaluación de riesgos completa y mitigar los riesgos adecuadamente.
¿Existe un enfoque diferente a la hora de utilizar la evaluación de riesgos para las directrices de la UE frente a las directrices ISO?
Las normas ISO no cubren directamente las evaluaciones de riesgos, pero las utilizamos como guía para las validaciones de salas blancas, en concreto la ISO 14644-1. Se revisan periódicamente y se crean nuevas normas continuamente. Los reglamentos de la UE, como los descritos en el Anexo 1, tratan las evaluaciones de riesgos de forma más directa. Es importante comprender la jerarquía de reglamentos, normas y directrices, siendo prioritarios los reglamentos ya que estos son los requisitos, mientras que las normas son las que guían para cumplir con dichos requisitos.
¿Existe alguna forma de realizar un muestreo de monitorización ambiental para detectar anaerobios en un entorno totalmente aerobio?
Es difícil tomar muestras de un organismo anaeróbico en un entorno totalmente aeróbico porque dichos organismos son incapaces de crecer en zonas ricas en oxígeno. Durante el proceso de la EMPQ, es importante comprender los factores ambientales que permiten el crecimiento de anaerobios. Normalmente, los anaerobios no prosperan en entornos ricos en oxígeno, pero hay excepciones con los anaerobios facultativos, como las especies de Propionibacterium, que pueden tolerar algunos niveles de oxígeno.

Normalmente son muy raros y a veces pasan desapercibidos durante el control de monitorización ambiental. Es importante comprender su proceso de fabricación y utilizar un enfoque basado en el riesgo para la toma de muestras. Por ejemplo, la contaminación anaeróbica puede producirse cuando se utilizan gases como el nitrógeno, y esto puede ayudar a proporcionar una sólida justificación científica para la aplicación de un riguroso protocolo de muestreo para analizar la presencia de anaerobios.
¿Cómo facilita la EMPQ el cumplimiento de la normativa y la preparación para auditorías en las empresas farmacéuticas?
Una EMPQ es un requisito reglamentario y constituye la justificación de la frecuencia y el muestreo rutinario de la monitorización ambiental. Si un riesgo no se aborda adecuadamente durante el proceso de la EMPQ, puede plantear riesgos de contaminación en sus procesos de fabricación futuros. Una EMPQ correctamente ejecutada garantiza que los riesgos se identifiquen y se mitiguen para evitar análisis inadecuados de la causa raíz o CAPA ineficaces. Una EMPQ demuestra una actitud proactiva y facilita el cumplimiento de la normativa, ya que proporciona información valiosa de la sala blanca en condiciones operativas y estáticas, permitiendo un programa integral de gestión de riesgos.
Si la secuenciación de ADN es el ensayo de referencia para las identificaciones, ¿cuál es la ventaja de utilizar la tecnología MALDI-TOF?
La secuenciación del ADN es el ensayo de referencia para las identificaciones, ya que es la metodología más precisa y robusta disponible, especialmente cuando se combina con el análisis filogenético exhaustivo proporcionado por nuestros servicios AccuGENX-ID®. Para la rutina de la monitorización ambiental, la tecnología MALDI-TOF (ya sea con nuestro sistema Axcess® o con nuestros servicios AccuPRO-ID®) puede proporcionar algunas ventajas sobre la secuenciación de ADN cuando se utiliza con la amplia base de datos de Charles River. El MALDI-TOF puede reducir el tiempo de obtención de resultados, proporcionar una solución de identificación económica y mejorar significativamente la calidad de la identificación microbiana en comparación con los métodos fenotípicos. Sin embargo, la secuenciación del ADN es el método preferido y aconsejado tanto para las muestras críticas (fallos de esterilidad o de llenado de medios, OOS y otras muestras de investigación) como para la línea de base y la cualificación de salas blancas, ya que ofrecen tiempos más rápido de resultados y mayor precisión. Si se utilizan métodos MALDI-TOF para muestras críticas y cualificación de salas blancas, el tiempo de obtención de resultados puede verse afectado por la necesidad de cultivos frescos y al posible tiempo añadido debido al back up de secuenciación ofrecemos con las muestras MALDI-TOF.
¿Puedo utilizar mi sistema in-house para identificar mis muestras de EMPQ y utilizar Accugenix® para las muestras rutinarias de monitorización ambiental?
La EMPQ es crucial para la estrategia de control de la contaminación de una empresa. Muchas empresas prefieren utilizar sus propios sistemas, pero es importante tener en cuenta qué base de datos se utiliza y si es coherente. El uso de una base de datos diferente para la EMPQ y para el muestreo ambiental rutinario podría dar lugar a incoherencias en la comparabilidad de los datos, ya que podría haber variaciones en la forma en que las diferentes bases de datos identifican los organismos. Lo mejor es utilizar la misma base de datos en todo el programa de identificación microbiana para obtener un análisis de datos coherente y fiable. Además, muchos sistemas internos tienen una base de datos clínica y poco representativa, lo que limita la utilidad de estos sistemas para su uso en instalaciones farmacéuticas. El resultado del uso de base de datos limitadas por su pequeño tamaño provoca un aumento del número de resultados de «no identificación» y de identificaciones erróneas, que pueden incrementar significativamente el coste global y el impacto en la calidad de un programa de identificación microbiana.
Descarga sugerida:
Artículo escrito por:
Micayla Hill y Charles River
Charles River Laboratories